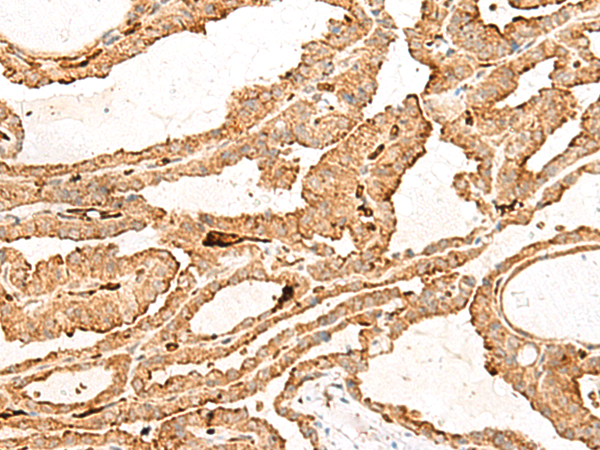

中文名稱: 兔抗HBG1/HBG2多克隆抗體
英文名稱: Anti-HBG1/HBG2 rabbit polyclonal antibody
別 名: hemoglobin subunit gamma 1/2; fetal hemoglobin; HBGA; HBGR; HBG-T2; HSGGL1; PRO2979; TNCY; HBG-T1
儲 存: 冷凍(-20℃)
宿 主: Rabbit
抗 原: HBG1/HBG2
反應種屬: Human
標 記 物: Unconjugate
克隆類型: rabbit polyclonal
Background:
The gamma globin genes (HBG1 and HBG2) are normally expressed in the fetal liver, spleen and bone marrow. Two gamma chains together with two alpha chains constitute fetal hemoglobin (HbF) which is normally replaced by adult hemoglobin (HbA) at birth. In some beta-thalassemias and related conditions, gamma chain production continues into adulthood. The two types of gamma chains differ at residue 136 where glycine is found in the G-gamma product (HBG2) and alanine is found in the A-gamma product (HBG1). The former is predominant at birth. The order of the genes in the beta-globin cluster is: 5'-epsilon -- gamma-G -- gamma-A -- delta -- beta--3'.
Applications:
ELISA, WB, IHC
Name of antibody:
HBG1/HBG2
Immunogen:
Fusion protein of human HBG1/HBG2
Full name:
hemoglobin subunit gamma 1/2
Synonyms:
fetal hemoglobin; HBGA; HBGR; HBG-T2; HSGGL1; PRO2979; TNCY; HBG-T1
SwissProt:
P69891/P69892
ELISA Recommended dilution:
5000-10000
IHC positive control:
Human thyroid cancer
IHC Recommend dilution:
40-200
WB Predicted band size:
16 kDa
WB Positive control:
Human plasma solution
WB Recommended dilution:
500-2000
技術規格

購物車
購物車 幫助
幫助
 021-54845833/15800441009
021-54845833/15800441009
